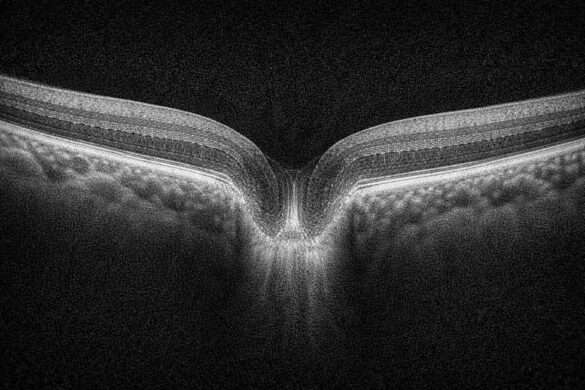

この記事はRNFL(視神経乳頭)の解析指標の基本である、RNFLサークルについて解説します。
解析指標の全体像については下記のページでまとめています。
 CIRRUS OCTのONH・RNFL解析とは?カラーマップと偏差マップの見方を解説
CIRRUS OCTのONH・RNFL解析とは?カラーマップと偏差マップの見方を解説 OCTでRNFLを評価するとき、よく出てくるのが「RNFLサークルスキャン」という解析方法。
でも、そこで表示される断層像が「どこを見てるのかよく分からない」と感じたことはないでしょうか?
実はこれ、「視神経乳頭の周囲をぐるっと一周スキャンした断面」を帯状に引き伸ばして表示している画像なんです。
RNFLサークルスキャンとは?
RNFLサークルは、視神経乳頭を中心に直径3.4mmの円を描いて、その円周に沿って神経線維層(RNFL)の厚みを測る解析です。
緑内障などでの線維層の菲薄化(うすくなる変化)を早期に検出するのに使われます。
この円周上をスキャンして得られたAスキャン(断層情報)を連続的につなぎ合わせることで、ぐるっと一周分の断面図=Bスキャン画像が作られます。
なぜ断層像が見慣れない形なのか?
このBスキャン画像、じつは円形の断面を引き延ばしたものなので、普通の断面とはまったく形が違います。
上下に波打ったような形や、左端と右端がつながっているように見えるのは、視神経の周囲を一周した結果を“平面”に並べているからです。
僕はホールケーキのフィルムをイメージしました。
読み方のポイントは?
- 断層像の上に見えるのがRNFLの厚み(上側の盛り上がり)
- RNFLが薄いところは「谷」のように見える
- 時計回りでの位置関係を意識して、どこに変化があるかを確認します
- TSNITグラフやセクター解析と合わせて読むと理解が深まります
まとめ
RNFLサークルスキャンの断層像は、ぐるっと一周した視神経の周囲の“厚みの記録”です。
見慣れるまでは不自然に見えるかもしれませんが、「円周を平らにした断面図」だと理解すれば、どこを見ているのかがスッキリします。
🔗関連記事
 眼科検査画像を重ねて比較・確認するための無料ツール集|緑内障フォロー・血管造影確認などに
眼科検査画像を重ねて比較・確認するための無料ツール集|緑内障フォロー・血管造影確認などに  視野検査TD・PDの違いとは?グレースケールの見方を解説
視野検査TD・PDの違いとは?グレースケールの見方を解説  【眼科医向け】OCT(眼底カメラ一体型)主要メーカー比較|導入前に知っておきたい選び方のポイント
【眼科医向け】OCT(眼底カメラ一体型)主要メーカー比較|導入前に知っておきたい選び方のポイント  【ニデックOCTをご使用の方へ】長眼軸データベース活用法|眼軸長が測れない施設でも使える推定ツール(β版)
【ニデックOCTをご使用の方へ】長眼軸データベース活用法|眼軸長が測れない施設でも使える推定ツール(β版)  0.5ミリ先
0.5ミリ先